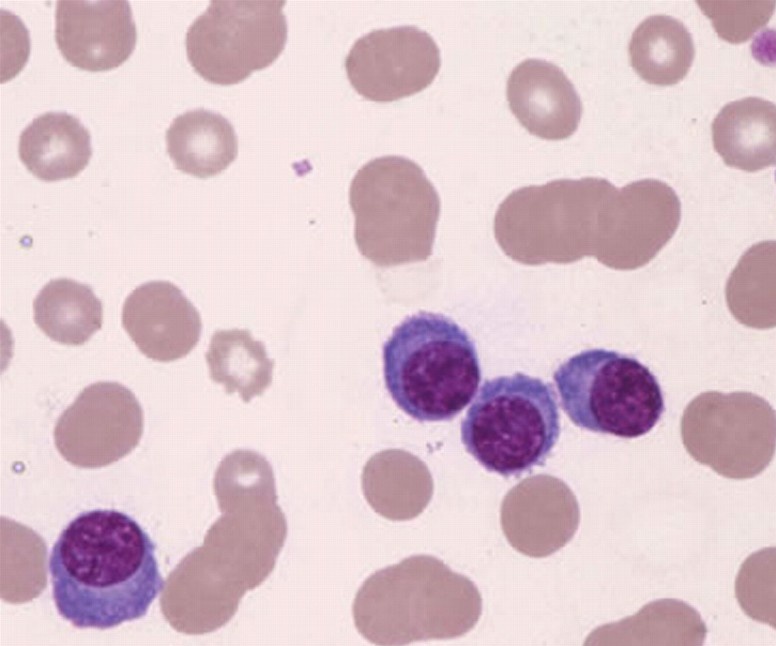
الجودة والتطوير tweet media

Sabitlenmiş Tweet

📄✨ اختبار SLLE على الأبواب؟
ادخل الاختبار وأنت جاهز 100% 💪
برنامج مكثّف ومركّز
للي هدفهم درجة عالية 🎯
🔎 ماذا ستحصل عليه؟
• تدريبات شاملة
• اختبارات محاكية
• شرح مبسّط ومفصّل لأكثر من 1600 سؤال
⏳ المقاعد محدودة
📲 للتسجيل والاستفسار:
wa.me/966533858571


العربية